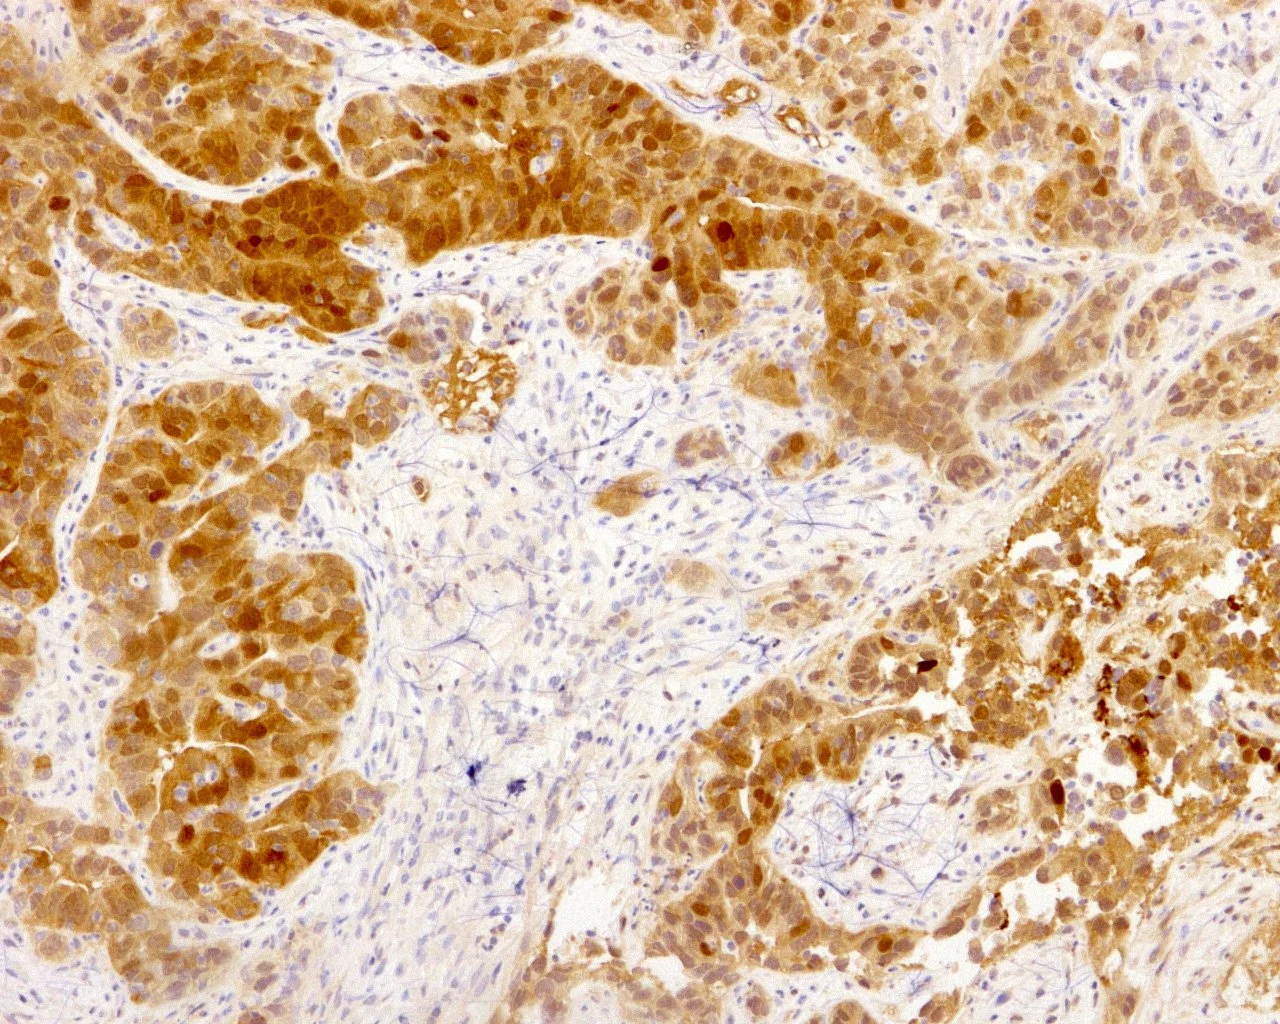

RESEARCH
Cancer is a multistep process that involves alterations in cell-autonomous and non-cell autonomous events that are modulated by metabolic factors. Our laboratory uses genetically engineered mouse models (GEMMs) of lung cancer, which recapitulate the genetics, histological progression and tissue microenvironment, to elucidate the interactions of tumor cell autonomous oncogenic events with alterations in tumor and whole-animal metabolism (Papagiannakopoulos, T. et al, Cell Metabolism, 2016). We recently pioneered novel CRISPR/Cas9-based somatic genome engineering in lung cancer GEMMs (Sánchez-Rivera, F. J. and Papagiannakopoulos, T. et al, Nature 2014). Using CRISPR/Cas9-based genome engineering, we have developed a platform to rapidly characterize the function of genes which are highly mutated in lung cancer, elucidate their mechanism of action and identify novel targeted therapies against complex genetic subtypes of lung cancer.
A major focus of our laboratory is to apply CRISPR/Cas9-based in vivo and in vitro approaches to study KRAS-driven lung cancer, the major subtype of lung cancer and one of the most aggressive and lethal solid tumors. Therapeutic options and outcomes for KRAS-driven cancers have remained virtually unchanged over the past thirty years. Specifically, we are investigating how genetic alterations in the metabolic pathways (e.g. NRF2/KEAP1, LKB1), which are observed in a large subset of lung cancers, can influence tumor initiation and progression by rewiring metabolic pathways. We use a combination of genetic and biochemical approaches to identify metabolic liabilities that can be exploited using novel targeted therapies. Since the establishment of our laboratory in October 2015, we have made significant progress in applying our approaches to characterize a major genetic subset of lung adenocarcinoma with NRF2/KEAP1 mutations (Ashouri et al., Nat. Comm, 2017; In Press: Romero R et al., Nature Medicine; Sayin VI et al., eLife).
Development of novel in vivo genome engineering approaches for cancer research
Metabolic reprogramming, oxidative stress and lung cancer
Kras-driven non-small cell lung cancer (NSCLC) remains one of the most aggressive and lethal solid tumors. ~20% of Kras-driven NSCLC acquire mutually exclusive activating mutations in the anti-oxidant transcription factor NRF2 or inactivating mutations in its negative regulator KEAP1. The anti-oxidant transcription factor NRF2 acts as the primary line of cellular defense against reactive oxygen species (ROS) by rewiring metabolism to maintain oxidative homeostasis
Using a combination of a Kras-driven genetically engineered mouse model and somatic CRISPR/Cas9 genome-engineering approaches we have demonstrated the functional importance of NRF2/KEAP1 pathway in lung tumorigenesis. Using both metabolomic and focused genetic screening methods we are systematically indentifying novel mechanisms underlying the role of Nrf2/Keap1 pathway in lung cancer. We find unique metabolic dependancies in Nrf2/Keap1 mutant lung cancer cells which we validate by both genetic and biochmeical approaches. These dependancies highlight metabolic vulnerabilities in cells with increased anti-oxidant production due to alteration in the Nrf2/Keap1 pathway, which can we are exploiting as novel metabolism-based therapeutic strategies for lung cancer.
Cancer develops from mutations and copy number alterations in oncogenes and tumor suppressor genes. Genome sequencing studies have identified a large collection of genetic alterations that occur in human cancers. However, the determination of which mutations are causally related to tumorigenesis remains a major challenge. Our lab is pioneering the use of GEMMs of lung cancer in combination with in vivo CRISPR/Cas9 genome engineering approaches to address the immediate need to systematically interrogate the complex catalog of mutations obtained from cancer genome sequencing studies.
In the era of personalized medicine, CRISPR/Cas9-based approaches provide invaluable tools to tackle the complexity of cancers. The extensive information recorded from an individual patient tumor can be functionally validated using a platform that makes use of both in vitro and in vivo CRIPSR/Cas9-based approaches. Once important functional variants are identified, genetic and drug screens can be performed to identify genotype-specific vulnerabilities that may pave the road to new personalized genotype-based therapies, which is the ultimate goal of precision medicine.
Overview
Genome Engineering
Sayin VI, Papagiannakopoulos T. Application of CRISPR-mediated genome engineering in cancer research.Cancer Lett. 2016 Mar 18. pii: S0304-3835(16)30179-3. doi: 10.1016/j.canlet.2016.03.029. [Epub ahead of print] PMID: 27000990
Sánchez-Rivera, F. J. *; Papagiannakopoulos, T.*; Romero, R.; Tammela, T.; Bauer, M. R.; Bhutkar, A.; Joshi, N.S.; Subbaraj, L.; Bronson, R. T.; Xue, X.; Jacks, T. Rapid modeling of cooperating genetic events in cancer through somatic genome editing. Nature. (2014), doi:10.1038/nature13906 *First Co-Author
Xue, W., Chen, S., Yin, H., Tammela, T., Papagiannakopoulos, T., Joshi, N. S., Cai, W., Yang, G., Bronson, R., Crowley, D. G., Zhang, F., Anderson, D. G., Sharp, P. A. & Jacks, T. CRISPR-mediated direct mutation of cancer genes in the mouse liver. Nature, doi:10.1038/nature13589 (2014).
McFadden DG*, Papagiannakopoulos T.*, Taylor-Weiner A*, Stewart C*, Carter SL*, Cibulskis K, Bhutkar A , McKenna A, Dooley A, Vernon A, Sougnez C, Malstrom S, Heimann M, Park J, Chen F, Farago AF, Dayton T, Shefler E, Gabriel S, Getz G, Jacks T. (2013) Genetic and clonal dissection of murine small cell lung cancer progression by genome sequencing. Cell 156, 1298-1311, doi:10.1016/j.cell.2014.02.031 (2014). *First Co-Authors
Lung Tumorigenesis
Elucidating the role of physiologic and metabolic factors in lung tumorigenesis
Circadian rhythm disruption promotes lung cancer
Despite extensive characterization of genetic events that contribute to cancer, the impact of environmental/physiologic factors on tumorigenesis remains poorly understood. A major consequence of a modern lifestyle is the disruption of circadian rhythms. A plethora of epidemiological studies have revealed that the risk for many types of cancer, including lung, is significantly higher among shift-workers. In 2010, the World Health Organization and the International Agency for Research on Cancer, published an assessment on carcinogenicity of shift-work which concluded: “shift-work that involves circadian disruption is probably carcinogenic to humans”. This raises many concerns, since in the US alone, it is estimated that 20% of the US work force is subjected to shifting work schedule.
Circadian rhythm disruption by shift-work is associated with greater risk for cancer development and poor prognosis, suggesting a putative tumor suppressive role for circadian rhythm homeostasis. Circadian rhythms are 24-hour oscillations that control a variety of biological processes in living systems, including two hallmarks of cancer, cell division and metabolism.
Using a GEMMs of lung cancer, we are characterizing the effects of circadian rhythm disruption on lung tumorigenesis. We demonstrate that both physiologic perturbation (jet lag) and genetic mutation of the central circadian clock components decreased survival and promoted lung tumor growth and progression.
Davidson SM, Papagiannakopoulos T, Olenchock BA, Heyman JE, Keibler MA, Luengo A, Bauer MR, Jha AK, O'Brien JP, Pierce KA, Gui DY, Sullivan LB, Wasylenko TM, Subbaraj L, Chin CR, Stephanopolous G, Mott BT, Jacks T, Clish CB, Vander Heiden MG. Environment Impacts the Metabolic Dependencies of Ras-Driven Non-Small Cell Lung Cancer. Cell Metab. 2016 Feb 3. pii: S1550-4131(16)00041-3. doi: 10.1016/j.cmet.2016.01.007. [Epub ahead of print]
Papagiannakopoulos, T., Bauer, M., Davidson, S., Heimann, M. , Subbaraj, L., Bhutkar, A., Bartlebaugh, J., Vander Heiden, M., Jacks, T. Circadian Rhythm Disruption Promotes Lung Tumorigenesis. Cell Metabolism. (2016).
Masri S, Papagiannakopeoulos T, Kinouchi K, Liu Y, Cervantes M, Baldi P, Jacks T, Sassone-Corsi P. Lung Adenocarcinoma Distally Rewires Hepatic Circadian Homeostasis. Cell. 2016; 165(4):896-909. PubMed [journal] PMID: 27153497